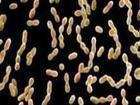

-
錐蟲病
628健康網為您分享有關錐蟲病的癥狀,錐蟲病的治療方法,錐蟲病的預防知識,錐蟲病的癥狀圖片,錐蟲病吃什么藥,錐蟲病怎么治...
-
咽部麻風
628健康網為您分享有關咽部麻風的癥狀,咽部麻風的治療方法,咽部麻風的預防知識,咽部麻風的癥狀圖片,咽部麻風吃什么藥,咽...
-
急性咽炎
628健康網為您分享有關急性咽炎的癥狀,急性咽炎的治療方法,急性咽炎的預防知識,急性咽炎的癥狀圖片,急性咽炎吃什么藥,急...
-
著色桿菌病
628健康網為您分享有關著色桿菌病的癥狀,著色桿菌病的治療方法,著色桿菌病的預防知識,著色桿菌病的癥狀圖片,著色桿菌病...
-
猴痘
628健康網為您分享有關猴痘的癥狀,猴痘的治療方法,猴痘的預防知識,猴痘的癥狀圖片,猴痘吃什么藥,猴痘怎么治療,猴痘患者食...
-
釉質發(fā)育不全
628健康網為您分享有關釉質發(fā)育不全的癥狀,釉質發(fā)育不全的治療方法,釉質發(fā)育不全的預防知識,釉質發(fā)育不全的癥狀圖片,釉...
-
咽扁桃體肥大
628健康網為您分享有關咽扁桃體肥大的癥狀,咽扁桃體肥大的治療方法,咽扁桃體肥大的預防知識,咽扁桃體肥大的癥狀圖片,咽...
-
二期梅毒
628健康網為您分享有關二期梅毒的癥狀,二期梅毒的治療方法,二期梅毒的預防知識,二期梅毒的癥狀圖片,二期梅毒吃什么藥,二...
-
急性扁桃體炎
628健康網為您分享有關急性扁桃體炎的癥狀,急性扁桃體炎的治療方法,急性扁桃體炎的預防知識,急性扁桃體炎的癥狀圖片,急...
-
腹股溝肉芽腫
628健康網為您分享有關腹股溝肉芽腫的癥狀,腹股溝肉芽腫的治療方法,腹股溝肉芽腫的預防知識,腹股溝肉芽腫的癥狀圖片,腹...
-
淋病
628健康網為您分享有關淋病的癥狀,淋病的治療方法,淋病的預防知識,淋病的癥狀圖片,淋病吃什么藥,淋病怎么治療,淋病患者食...
-
妊娠合并病毒性肝炎
628健康網為您分享有關妊娠合并病毒性肝炎的癥狀,妊娠合并病毒性肝炎的治療方法,妊娠合并病毒性肝炎的預防知識,妊娠合并...
-
埃博拉病毒病
628健康網為您分享有關埃博拉病毒病的癥狀,埃博拉病毒病的治療方法,埃博拉病毒病的預防知識,埃博拉病毒病的癥狀圖片,埃...
-
妊娠合并梅毒
628健康網為您分享有關妊娠合并梅毒的癥狀,妊娠合并梅毒的治療方法,妊娠合并梅毒的預防知識,妊娠合并梅毒的癥狀圖片,妊...
-
慢性扁桃體炎
628健康網為您分享有關慢性扁桃體炎的癥狀,慢性扁桃體炎的治療方法,慢性扁桃體炎的預防知識,慢性扁桃體炎的癥狀圖片,慢...
-
皮膚利什曼病
628健康網為您分享有關皮膚利什曼病的癥狀,皮膚利什曼病的治療方法,皮膚利什曼病的預防知識,皮膚利什曼病的癥狀圖片,皮...
-
品他病
628健康網為您分享有關品他病的癥狀,品他病的治療方法,品他病的預防知識,品他病的癥狀圖片,品他病吃什么藥,品他病怎么治...
-
皮膚絲蟲病
628健康網為您分享有關皮膚絲蟲病的癥狀,皮膚絲蟲病的治療方法,皮膚絲蟲病的預防知識,皮膚絲蟲病的癥狀圖片,皮膚絲蟲病...
-
溶組織內阿米巴病
628健康網為您分享有關溶組織內阿米巴病的癥狀,溶組織內阿米巴病的治療方法,溶組織內阿米巴病的預防知識,溶組織內阿米巴...
-
丘疹壞死性結核疹
628健康網為您分享有關丘疹壞死性結核疹的癥狀,丘疹壞死性結核疹的治療方法,丘疹壞死性結核疹的預防知識,丘疹壞死性結核...
-
肉毒中毒
628健康網為您分享有關肉毒中毒的癥狀,肉毒中毒的治療方法,肉毒中毒的預防知識,肉毒中毒的癥狀圖片,肉毒中毒吃什么藥,肉...
-
三期梅毒
628健康網為您分享有關三期梅毒的癥狀,三期梅毒的治療方法,三期梅毒的預防知識,三期梅毒的癥狀圖片,三期梅毒吃什么藥,三...
-
蘇格蘭腦炎
628健康網為您分享有關蘇格蘭腦炎的癥狀,蘇格蘭腦炎的治療方法,蘇格蘭腦炎的預防知識,蘇格蘭腦炎的癥狀圖片,蘇格蘭腦炎...
-
性病性淋巴肉芽腫
628健康網為您分享有關性病性淋巴肉芽腫的癥狀,性病性淋巴肉芽腫的治療方法,性病性淋巴肉芽腫的預防知識,性病性淋巴肉芽...
-
陰莖結核疹
628健康網為您分享有關陰莖結核疹的癥狀,陰莖結核疹的治療方法,陰莖結核疹的預防知識,陰莖結核疹的癥狀圖片,陰莖結核疹...
-
雅司病
628健康網為您分享有關雅司病的癥狀,雅司病的治療方法,雅司病的預防知識,雅司病的癥狀圖片,雅司病吃什么藥,雅司病怎么治...
-
自由生活阿米巴感染
628健康網為您分享有關自由生活阿米巴感染的癥狀,自由生活阿米巴感染的治療方法,自由生活阿米巴感染的預防知識,自由生活...
-
芽生菌病
628健康網為您分享有關芽生菌病的癥狀,芽生菌病的治療方法,芽生菌病的預防知識,芽生菌病的癥狀圖片,芽生菌病吃什么藥,芽...
-
乙型肝炎抗原血癥
628健康網為您分享有關乙型肝炎抗原血癥的癥狀,乙型肝炎抗原血癥的治療方法,乙型肝炎抗原血癥的預防知識,乙型肝炎抗原血...
-
豬帶絳蟲病
628健康網為您分享有關豬帶絳蟲病的癥狀,豬帶絳蟲病的治療方法,豬帶絳蟲病的預防知識,豬帶絳蟲病的癥狀圖片,豬帶絳蟲病...
-
陰虱病
628健康網為您分享有關陰虱病的癥狀,陰虱病的治療方法,陰虱病的預防知識,陰虱病的癥狀圖片,陰虱病吃什么藥,陰虱病怎么治...
-
戰(zhàn)壕熱
628健康網為您分享有關戰(zhàn)壕熱的癥狀,戰(zhàn)壕熱的治療方法,戰(zhàn)壕熱的預防知識,戰(zhàn)壕熱的癥狀圖片,戰(zhàn)壕熱吃什么藥,戰(zhàn)壕熱怎么治...
-
衣原體感染癥
628健康網為您分享有關衣原體感染癥的癥狀,衣原體感染癥的治療方法,衣原體感染癥的預防知識,衣原體感染癥的癥狀圖片,衣...
-
疣狀皮膚結核
628健康網為您分享有關疣狀皮膚結核的癥狀,疣狀皮膚結核的治療方法,疣狀皮膚結核的預防知識,疣狀皮膚結核的癥狀圖片,疣...
-
組織胞漿菌病
628健康網為您分享有關組織胞漿菌病的癥狀,組織胞漿菌病的治療方法,組織胞漿菌病的預防知識,組織胞漿菌病的癥狀圖片,組...
-
異尖線吸蟲蚴移行癥
628健康網為您分享有關異尖線吸蟲蚴移行癥的癥狀,異尖線吸蟲蚴移行癥的治療方法,異尖線吸蟲蚴移行癥的預防知識,異尖線吸...
-
乙肝大三陽
628健康網為您分享有關乙肝大三陽的癥狀,乙肝大三陽的治療方法,乙肝大三陽的預防知識,乙肝大三陽的癥狀圖片,乙肝大三陽...
-
醫(yī)院內感染
628健康網為您分享有關醫(yī)院內感染的癥狀,醫(yī)院內感染的治療方法,醫(yī)院內感染的預防知識,醫(yī)院內感染的癥狀圖片,醫(yī)院內感染...
-
口蹄疫
628健康網為您分享有關口蹄疫的癥狀,口蹄疫的治療方法,口蹄疫的預防知識,口蹄疫的癥狀圖片,口蹄疫吃什么藥,口蹄疫怎么治...
-
乙肝小三陽
628健康網為您分享有關乙肝小三陽的癥狀,乙肝小三陽的治療方法,乙肝小三陽的預防知識,乙肝小三陽的癥狀圖片,乙肝小三陽...
-
羊痘
628健康網為您分享有關羊痘的癥狀,羊痘的治療方法,羊痘的預防知識,羊痘的癥狀圖片,羊痘吃什么藥,羊痘怎么治療,羊痘患者食...
-
毛狀白斑
628健康網為您分享有關毛狀白斑的癥狀,毛狀白斑的治療方法,毛狀白斑的預防知識,毛狀白斑的癥狀圖片,毛狀白斑吃什么藥,毛...
-
尋常狼瘡
628健康網為您分享有關尋常狼瘡的癥狀,尋常狼瘡的治療方法,尋常狼瘡的預防知識,尋常狼瘡的癥狀圖片,尋常狼瘡吃什么藥,尋...
-
血吸蟲尾蚴性皮炎
628健康網為您分享有關血吸蟲尾蚴性皮炎的癥狀,血吸蟲尾蚴性皮炎的治療方法,血吸蟲尾蚴性皮炎的預防知識,血吸蟲尾蚴性皮...
-
一期梅毒
628健康網為您分享有關一期梅毒的癥狀,一期梅毒的治療方法,一期梅毒的預防知識,一期梅毒的癥狀圖片,一期梅毒吃什么藥,一...
-
厭氧菌感染
628健康網為您分享有關厭氧菌感染的癥狀,厭氧菌感染的治療方法,厭氧菌感染的預防知識,厭氧菌感染的癥狀圖片,厭氧菌感染...
-
原發(fā)性皮膚結核綜合征
628健康網為您分享有關原發(fā)性皮膚結核綜合征的癥狀,原發(fā)性皮膚結核綜合征的治療方法,原發(fā)性皮膚結核綜合征的預防知識...
-
中間型鏈球菌感染
628健康網為您分享有關中間型鏈球菌感染的癥狀,中間型鏈球菌感染的治療方法,中間型鏈球菌感染的預防知識,中間型鏈球菌感...
-
足菌腫
628健康網為您分享有關足菌腫的癥狀,足菌腫的治療方法,足菌腫的預防知識,足菌腫的癥狀圖片,足菌腫吃什么藥,足菌腫怎么治...
-
肝瘟
628健康網為您分享有關肝瘟的癥狀,肝瘟的治療方法,肝瘟的預防知識,肝瘟的癥狀圖片,肝瘟吃什么藥,肝瘟怎么治療,肝瘟患者食...